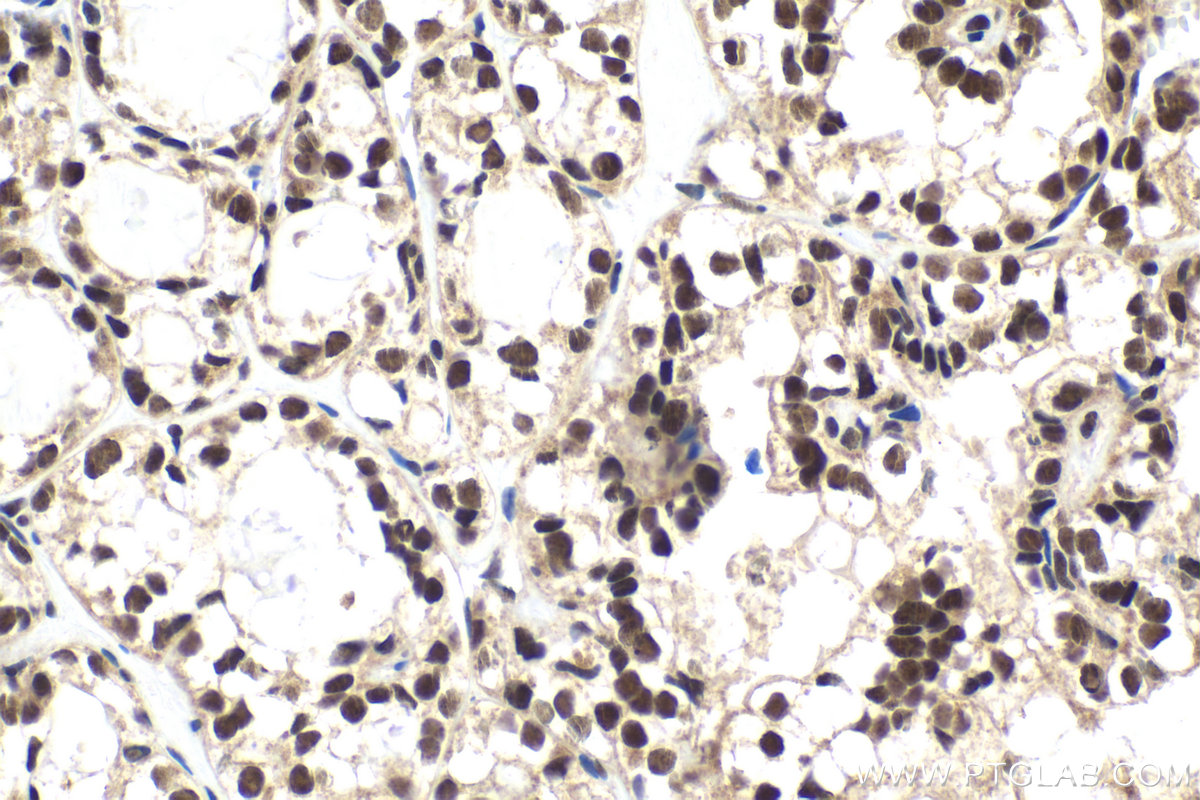

验证数据展示
经过测试的应用
| Positive WB detected in | HEK-293 cells, HeLa cells, C6 cells, mouse brain tissue, rat brain tissue |
| Positive IP detected in | HEK-293 cells |
| Positive IHC detected in | human thyroid cancer tissue Note: suggested antigen retrieval with TE buffer pH 9.0; (*) Alternatively, antigen retrieval may be performed with citrate buffer pH 6.0 |
推荐稀释比
| 应用 | 推荐稀释比 |
|---|---|
| Western Blot (WB) | WB : 1:2000-1:16000 |
| Immunoprecipitation (IP) | IP : 0.5-4.0 ug for 1.0-3.0 mg of total protein lysate |
| Immunohistochemistry (IHC) | IHC : 1:500-1:2000 |
| It is recommended that this reagent should be titrated in each testing system to obtain optimal results. | |
| Sample-dependent, Check data in validation data gallery. | |
产品信息
10617-1-AP targets ING4 in WB, IHC, IF, IP, ELISA applications and shows reactivity with human, mouse, rat samples.
| 经测试应用 | WB, IHC, IP, ELISA Application Description |
| 文献引用应用 | WB, IHC, IF, IP |
| 经测试反应性 | human, mouse, rat |
| 文献引用反应性 | human, mouse |
| 免疫原 |
CatNo: Ag0960 Product name: Recombinant human ING4 protein Source: e coli.-derived, PGEX-4T Tag: GST Domain: 1-249 aa of BC007781 Sequence: MAAGMYLEHYLDSIENLPFELQRNFQLMRDLDQRTEDLKAEIDKLATEYMSSARSLSSEEKLALLKQIQEAYGKCKEFGDDKVQLAMQTYEMVDKHIRRLDTDLARFEADLKEKQIESSDYDSSSSKGKKKGRTQKEKKAARARSKGKNSDEEAPKTAQKKLKLVRTSPEYGMPSVTFGSVHPSDVLDMPVDPNEPTYCLCHQVSYGEMIGCDNPDCSIEWFHFACVGLTTKPRGKWFCPRCSQERKKK 种属同源性预测 |
| 宿主/亚型 | Rabbit / IgG |
| 抗体类别 | Polyclonal |
| 产品类型 | Antibody |
| 全称 | inhibitor of growth family, member 4 |
| 别名 | p29ING4, Inhibitor of growth protein 4 |
| 计算分子量 | 29 kDa |
| 观测分子量 | 29 kDa |
| GenBank蛋白编号 | BC007781 |
| 基因名称 | ING4 |
| Gene ID (NCBI) | 51147 |
| RRID | AB_2127940 |
| 偶联类型 | Unconjugated |
| 形式 | Liquid |
| 纯化方式 | Antigen affinity purification |
| UNIPROT ID | Q9UNL4 |
| 储存缓冲液 | PBS with 0.02% sodium azide and 50% glycerol, pH 7.3. |
| 储存条件 | Store at -20°C. Stable for one year after shipment. Aliquoting is unnecessary for -20oC storage. |
背景介绍
ING4, also named as p29ING4, belongs to the ING family. It is a component of the HBO1 complex which has a histone H4-specific acetyltransferase activity, a reduced activity toward histone H3 and is responsible for the bulk of histone H4 acetylation in vivo. It may inhibit tumor progression by modulating the transcriptional output of signaling pathways which regulate cell proliferation. ING4 can suppress brain tumor angiogenesis through transcriptional repression of RELA/NFKB3 target genes when complexed with RELA. It may also specifically suppress loss of contact inhibition elicited by activated oncogenes such as MYC. Represses hypoxia inducible factor's (HIF) activity by interacting with HIF prolyl hydroxylase 2 (EGLN1). ING4 is a tumor suppressor gene that interacts with NFkB and represses its transcriptional activity. Several lines of evidence suggest that the tumor suppressor gene ING4, NFkB and its target genes matrix metalloproteases MMP-2, MMP-9 and u-PA are critically involved in tumor invasion. This antibody is a rabbit polyclonal antibody raised against full length human ING4 antigen.
实验方案
| Product Specific Protocols | |
|---|---|
| IHC protocol for ING4 antibody 10617-1-AP | Download protocol |
| IP protocol for ING4 antibody 10617-1-AP | Download protocol |
| WB protocol for ING4 antibody 10617-1-AP | Download protocol |
| Standard Protocols | |
|---|---|
| Click here to view our Standard Protocols |
发表文章
| Species | Application | Title |
|---|---|---|
Adv Sci (Weinh) Inhibition of CK2/ING4 Pathway Facilitates Non-Small Cell Lung Cancer Immunotherapy | ||
Blood The Hbo1-Brd1/Brpf2 complex is responsible for global acetylation of H3K14 and required for fetal liver erythropoiesis. | ||
Cancer Res Transient Induction of ING4 by MYC Drives Prostate Epithelial Cell Differentiation and its Disruption Drives Prostate Tumorigenesis. | ||
Oncogene Aberrant CREB1 activation in prostate cancer disrupts normal prostate luminal cell differentiation. | ||
Carcinogenesis Role of ING4 in human melanoma cell migration, invasion and patient survival. | ||
Mol Cell Biol The ING4 tumor suppressor attenuates NF-kappaB activity at the promoters of target genes. |